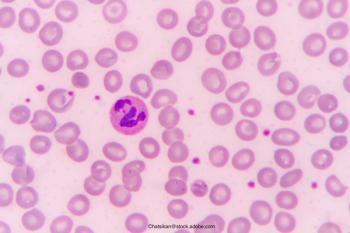

Two possibly curative gene therapies for the disease, which disproportionately affects Black people, are under consideration by the FDA.

Two possibly curative gene therapies for the disease, which disproportionately affects Black people, are under consideration by the FDA.

Delayed prophylaxis start and intermediate dose intensity of factor VIII prevents bleeds, but at a cost of more joint damage and possibly a lower QOL.

Years of steady price increases have made access to the essential medicine more difficult for millions of Americans with diabetes.

STAQ, a 503B outsourcing facility, started making desmopressin nasal spray after Ferring Pharmaceuticals suspended production nearly three years ago.

Critics of PBM's say that the high number of exclusions narrows patient options and make medications financially inaccessible.

As many as 10 Humira biosimilars may be on the US market before 2023 is over. AbbVie has taken several steps to protect its revenues, including the launches of Skyrizi and Rinvoq.

Pradaxa (dabigatran) and Coumadin (warfarin) came out even in this randomized study. The Brazilian researchers who conducted the study said one explanation for the result is that use of Coumadin was exceptionally well managed because the patients were enrolled a study.

US Preventive Services Task Force hasn't endorsed screening for atrial fibrillation. Findings from these two studies might factor into a reconsideration.

The review focused on Remicade (infliximab) and Enbrel (etanercept). The annualized discontinuation rate was 21% among patients who had undergone nonmedical switching to biosimilars. However, the rates were similar to those found in some separate analyses of patients on reference biologics.

Several provisions in the law are designed to protect and foster the biosimilar market. But some representatives of the sector see CMS drug price negotiation as a threat to profit margins.

Some companies are using the interchangeability designation as a marketing ploy.

The Inflation Reduction Act puts a $35 cap on monthly out-of-pocket expenses for insulin. The catch: It applies only to people covered by Medicare. The competition gearing up could drive down costs for others.

New research should give expectant mothers some peace of mind.

Humira may face competition from multiple generics next year, but an octet of other biologics may also see competition this decade.

The price of the biosimilar may also be persuasive for patients.
The average sales price (ASP) for biosimilars of Neupogen has declined more than 50% since these lower cost agents began to be sold in 2015.

Circle 2023 on your calendar. That's when as many as 11 biosimilars to Humira are headed for the US market.

There is now a mad scramble to gain interchangeable status for biosimilars, but the meaning and significance of this appellation haven't yet been worked out for health care consumers or the manufacturing community.

In studies presented this month at the European E-Congress of Rheumatology 2020, investigators revealed positive findings for the infliximab biosimilar CT-P13 (Inflectra, Remsima), which is developed by Celltrion of Incheon, Republic of Korea.

Published: March 10th 2023 | Updated: